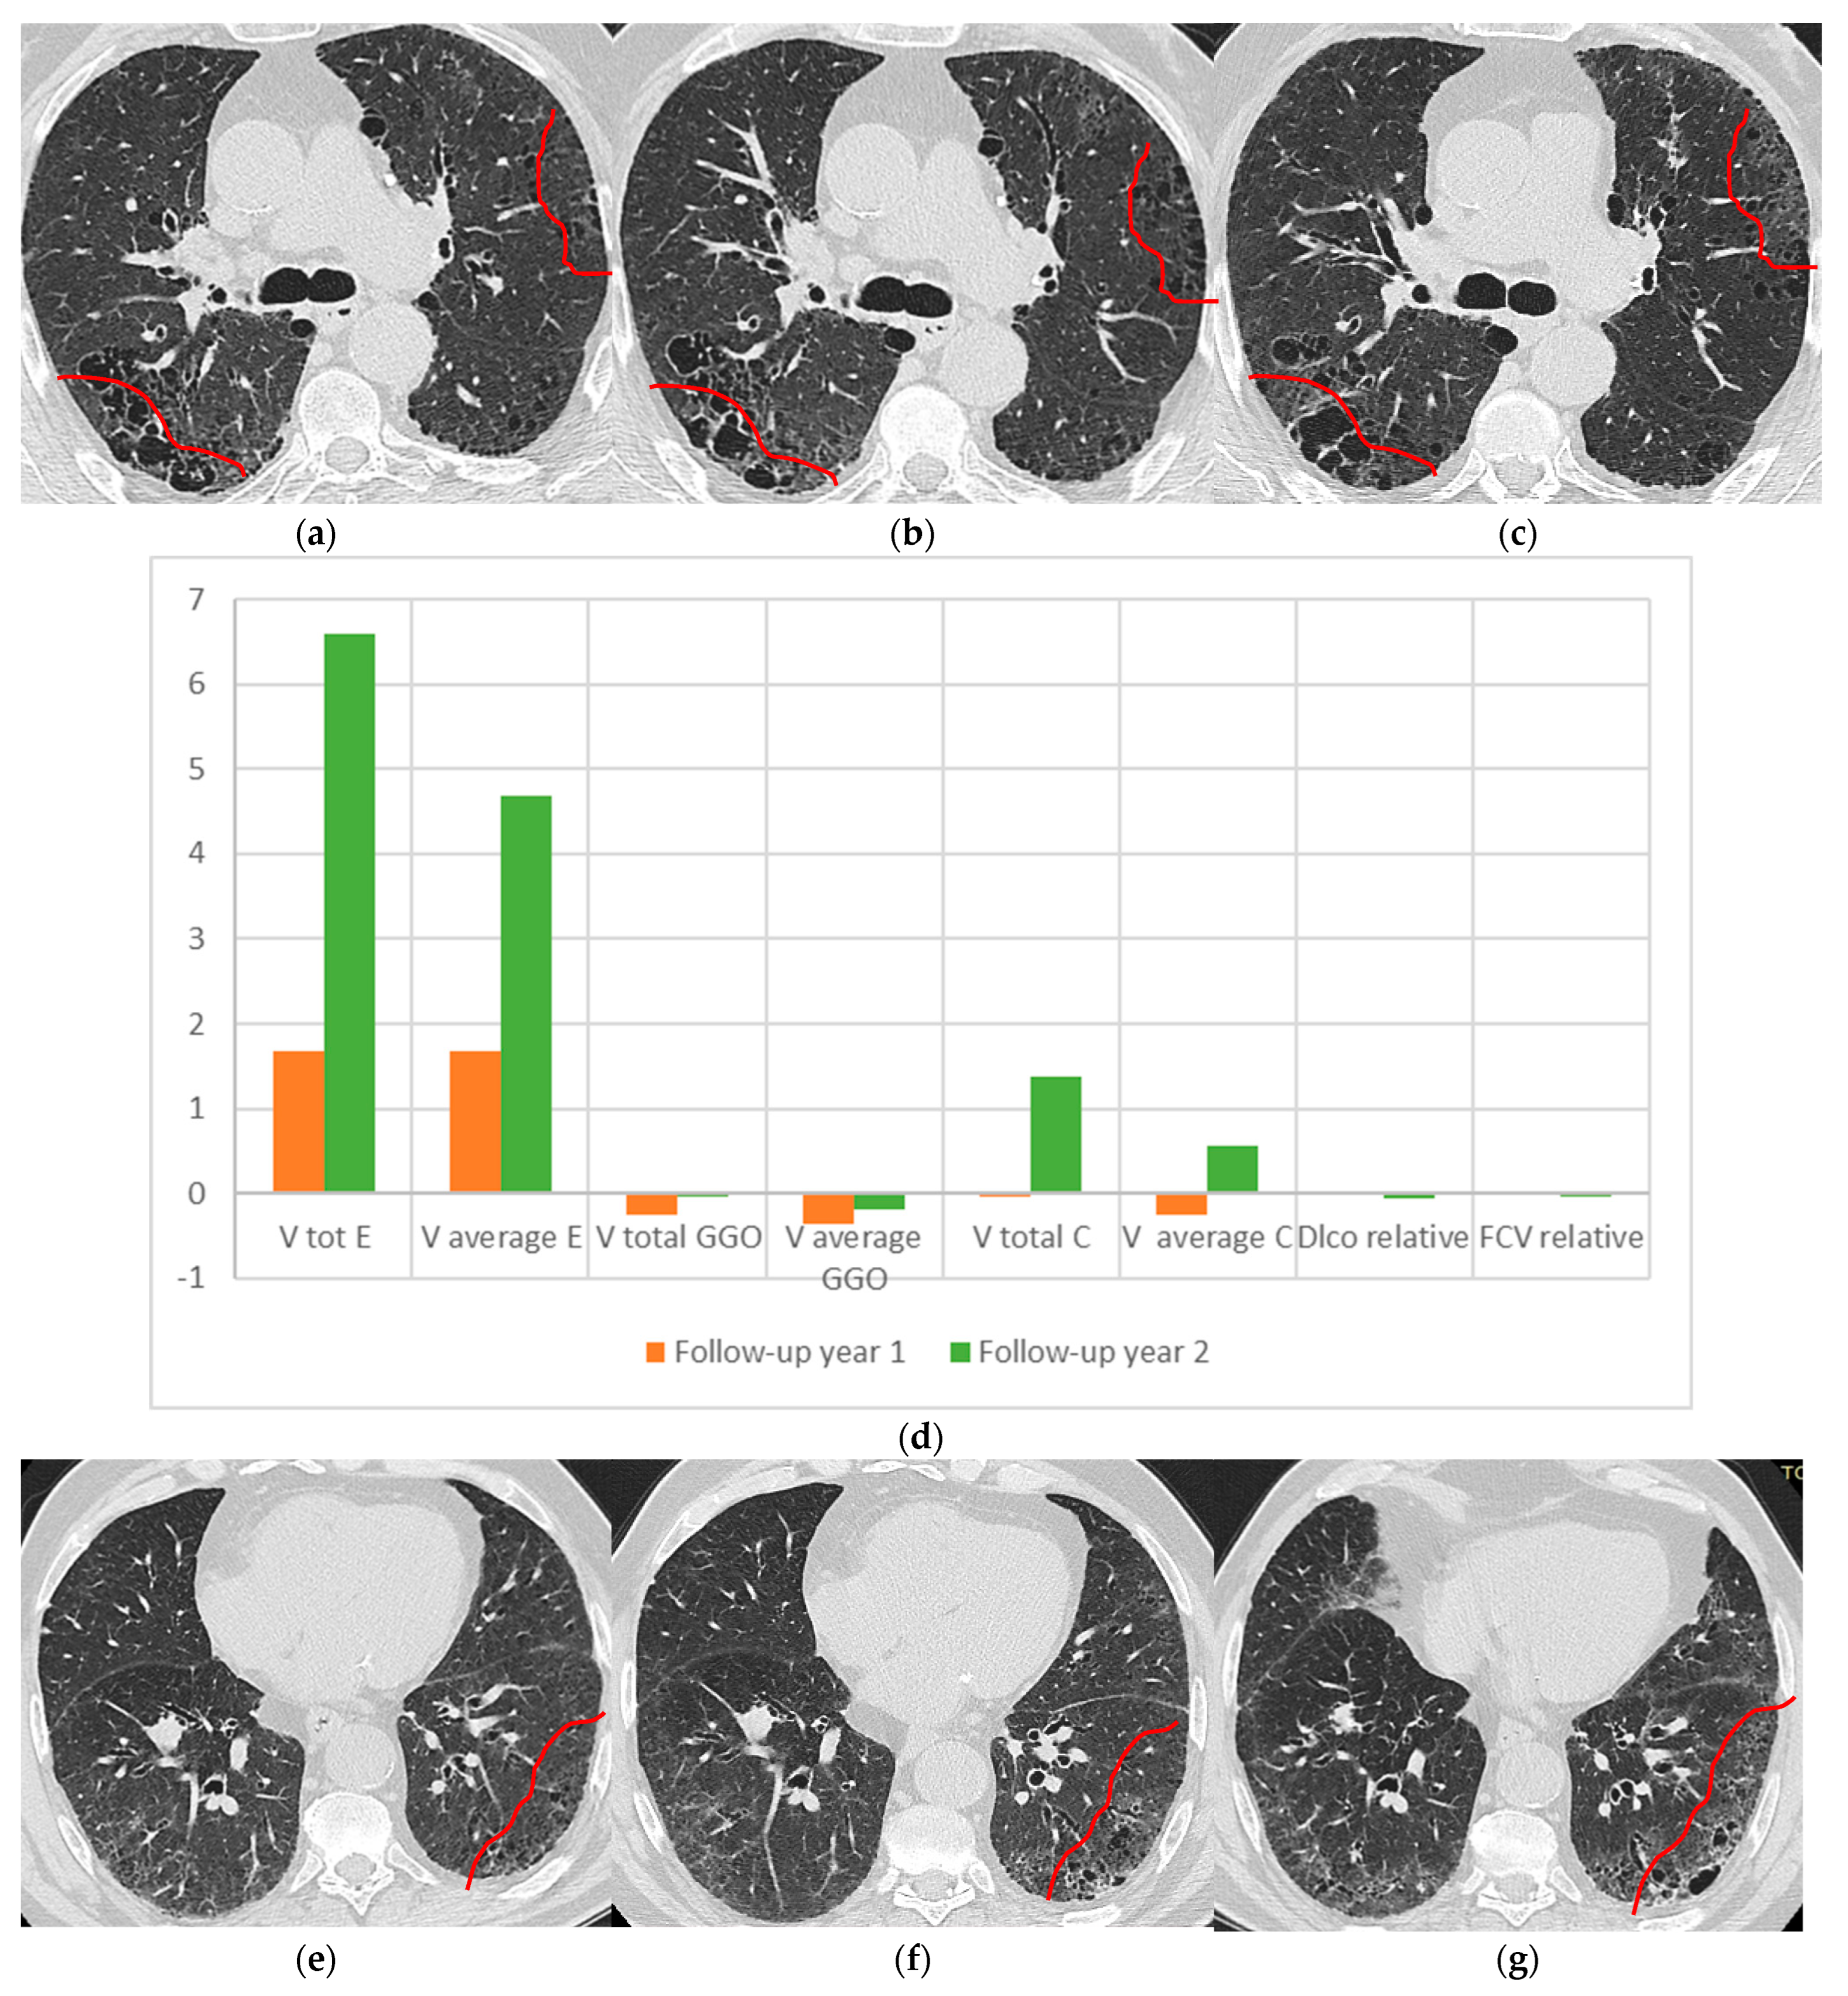
Medicina 58 01288 g002a Medicina 58 01288 g002a

Enhancing Imagistic Interstitial Lung Disease Diagnosis by Using Complex Networks
Abstract
1. Introduction
1.1. DILD Early Diagnosis
1.2. DILDs Evolution and Imagistic Diagnosis
1.3. Computer-Aided Diagnosis
1.4. Hypothesis to Be Explored
2. Materials and Methods
2.1. Lot Selection
- Each patient was diagnosed by at least 3 lung specialists, with 5+ years’ experience in DILD/IPF.
- Each CT qualified as HRCT, with parameters constant throughout the lot (further described in Section 2.2).
- All pathological patients have imagistic monitoring spanning at least 1 year.
- For each investigation, further data are available: DLco, FEV, age, sex, clinical outcome.
- All CTs have annotations: full CT descriptions developed by the centers’ specialists following the MDD.
- Patients unwilling to come for yearly follow-up imaging.
- Patients with poor quality HRCT imaging, with artifacts or slice thicker than 1.5 mm.
- Presence of severe associate pathology such as hepatic cirrhosis, neurodegenerative disease, neuro-psychiatric disease, severe heart failure, etc.
- Lack of freely expressed consent (from the observation sheet and/or lack of discernment).
2.2. Imaging Parameters
2.3. Selecting the Pathological Imagistic Alterations
2.4. Computer-Enhancing the Data
2.5. Selecting Relevant Metrics
3. Results
3.1. Case Reports
3.2. Progression Speed
3.3. Testing for Early Detection
4. Discussion
5. Conclusions
Author Contributions
Funding
Institutional Review Board Statement
Informed Consent Statement
Data Availability Statement
Conflicts of Interest
Abbreviation
| AIP | Acute interstitial pneumonia |
| CAD | Computer-aided diagnosis |
| CN | Complex networks |
| CPFE | Combined pulmonary fibrosis and emphysema |
| CT | Computer tomography |
| DILD | Diffuse interstitial lung diseases |
| DIP | Desquamative interstitial pneumonia, |
| DILD | Diffuse interstitial lung diseases |
| Dlco | Diffusing capacity of the lungs for carbon monoxide |
| FVC | Forced vital capacity |
| GE | General electrics |
| GGO | Ground glass opacity |
| HRCT | High resolution computed tomography |
| HPc | Chronic hypersensitivity pneumonitis |
| HU | Hounsfield unit |
| ILD | Interstitial lung diseases |
| IPF | Idiopathic pulmonary fibrosis |
| LAM | Lymphangiomyomatosis |
| LCH | Langerhans cell histiocytosis |
| LIP | Lymphoid interstitial pneumonia |
| NSIP | Non-specific interstitial pneumonia |
| MDD | Multidisciplinary discussion |
| OP | Organizing pneumonitis |
| PAP | Pulmonary alveolar proteinosis |
| PCR | Polymerase chain reaction |
| PFT | Pulmonary function test |
| PF-ILD | Progressive fibrosing interstitial lung disease |
| PPFE | Pleuroparenchymal fibroelastosis |
| RB-ILD | Respiratory bronchiolitis-associated interstitial lung disease |
| S | Sarcoidosis |
| SPL | Secondary pulmonary lobule |
| UIP | Usual interstitial pneumonia |
References
- Travis, W.D.; Costabel, U.; Hansell, D.M.; King, T.E., Jr.; Lynch, D.A.; Nicholson, A.G.; Ryerson, C.J.; Ryu, J.H.; Selman, M.; Wells, A.U.; et al. An official American Thoracic Society/European Respiratory Society statement: Update of the international multidisciplinary classification of the idiopathic interstitial pneumonias. Am. J. Respir. Crit. Care Med. 2013, 188, 733–748. [Google Scholar] [CrossRef] [PubMed]
- Meyer, K.C. Diagnosis and management of interstitial lung disease. Transl. Respir. Med. 2014, 2, 4. [Google Scholar] [CrossRef]
- Tomassetti, S.; Ravaglia, C.; Poletti, V. Diffuse parenchymal lung disease. Eur. Respir. Rev. 2017, 26, 170004. [Google Scholar] [CrossRef]
- Guo, B.; Wang, L.; Xia, S.; Mao, M.; Qian, W.; Peng, X.; Zheng, Z.; Chen, R.; Han, Q.; Luo, Q. The interstitial lung disease spectrum under a uniform diagnostic algorithm: A retrospective study of 1,945 individuals. J. Thorac. Dis. 2020, 12, 3688–3696. [Google Scholar] [CrossRef] [PubMed]
- American Thoracic Society. Idiopathic Pulmonary Fibrosis: Diagnosis and Treatment. Am. J. Respir. Crit. Care Med. 2000, 161, 646–664. [Google Scholar] [CrossRef] [PubMed]
- Manolescu, D.; Davidescu, L.; Traila, D.; Oancea, C.; Tudorache, V. The reliability of lung ultrasound in assessment of idiopathic pulmonary fibrosis. Clin. Interv. Aging 2018, 13, 437–449. [Google Scholar] [CrossRef]
- Simonyan, K.; Zisserman, A. Very Deep Convolutional Networks for Large-Scale Image Recognition. arXiv 2015. [Google Scholar] [CrossRef]
- Li, Q.; Cai, W.; Wang, X.; Zhou, Y.; Feng, D.D.; Chen, M. Medical image classification with convolutional neural network. In Proceedings of the 2014 13th International Conference on Control Automation Robotics & Vision (ICARCV), Singapore, 10–12 December 2014; pp. 844–848. [Google Scholar] [CrossRef]
- Walsh, S.L.F.; Calandriello, L.; Silva, M.; Sverzellati, N. Deep learning for classifying fibrotic lung disease on high-resolution computed tomography: A case-cohort study. Lancet Respir. Med. 2018, 6, 837–845. [Google Scholar] [CrossRef]
- Trusculescu, A.A.; Manolescu, D.; Tudorache, E.; Oancea, C. Deep learning in interstitial lung disease—How long until daily practice. Eur. Radiol. 2020, 30, 6285–6292. [Google Scholar] [CrossRef]
- Hatabu, H.; Hunninghake, G.M.; Lynch, D.A. Interstitial Lung Abnormality: Recognition and Perspectives. Radiology 2019, 291, 1–3. [Google Scholar] [CrossRef]
- Hieba, E.G.; Shaimaa, E.E.; Dina, S.S.; Noha, A.O. Diffusion lung capacity for carbon monoxide correlates with HRCT findings in patients with diffuse parenchymal lung disease. Egypt. J. Bronchol. 2020, 14, 1–9. [Google Scholar] [CrossRef]
- Kim, H.C.; Lee, J.H.; Chae, E.J.; Song, J.S.; Song, J.W. Long-term clinical course and outcome of interstitial pneumonia with autoimmune features. Respirology 2019, 25, 636–643. [Google Scholar] [CrossRef] [PubMed]
- Brown, K.K.; Inoue, Y.; Flaherty, K.R.; Martinez, F.J.; Cottin, V.; Bonella, F.; Cerri, S.; Danoff, S.K.; Jouneau, S.; Goeldner, R.; et al. Predictors of mortality in subjects with progressive fibrosing interstitial lung diseases. Respirology 2022, 27, 294–300. [Google Scholar] [CrossRef]
- Hussein, K.; Shaaban, L.H.; Mohamed, E. Correlation of high resolution CT patterns with pulmonary function tests in patients with interstitial lung diseases. Egypt. J. Chest Dis. Tuberc. 2016, 65, 681–688. [Google Scholar] [CrossRef]
- Oancea, V.C.; Fira-Mlădinescu, O.; Tudorache, V. Tratat de Pneumologie pentru medici rezidenti. In Capitolul 3. Metode de Investigatie Imagistica a Patologiei Pulmonare; Victor Babeș: Timișoara, România, 2021; pp. 42–59. [Google Scholar]
- Lee, S.H.; Park, J.S.; Kim, S.Y.; Kim, D.S.; Kim, Y.W.; Chung, M.P.; Uh, S.T.; Park, C.S.; Park, S.W.; Jeong, S.H.; et al. Comparison of CPI and GAP models in patients with idiopathic pulmonary fibrosis: A nationwide cohort study. Sci. Rep. 2018, 8, 4784. [Google Scholar] [CrossRef]
- Hyldgaard, C.; Hilberg, O.; Bendstrup, E. Validation of GAP score in Danish patients diagnosed with idiopathic pulmonary fibrosis. Eur. Respir. J. 2013, 42 (Suppl. S57), 2367. Available online: https://erj.ersjournals.com/content/42/Suppl_57/P2367 (accessed on 15 June 2022).
- Ryerson, C.J.; Vittinghoff, E.; Ley, B.; Lee, J.S.; Mooney, J.J.; Jones, K.D.; Elicker, B.M.; Wolters, P.J.; Koth, L.L.; King, T.E.; et al. Predicting Survival across Chronic Interstitial Lung Disease. Chest 2014, 145, 723–728. [Google Scholar] [CrossRef]
- Walsh, S.L.; Kolb, M. Radiological diagnosis of interstitial lung disease: Is it all about pattern recognition? Eur. Respir. J. 2018, 52, 1801321. [Google Scholar] [CrossRef]
- Mycophenolate Mofetil Improves Lung Function in Connective Tissue Disease-Associated Interstitial Lung Disease-PubMed. Available online: https://pubmed.ncbi.nlm.nih.gov/23457378/ (accessed on 20 June 2022).
- Morisset, J.; Johannson, K.A.; Vittinghoff, E.; Aravena, C.; Elicker, B.M.; Jones, K.D.; Fell, C.D.; Manganas, H.; Dubé, B.-P.; Wolters, P.J.; et al. Use of Mycophenolate Mofetil or Azathioprine for the Management of Chronic Hypersensitivity Pneumonitis. Chest 2017, 151, 619–625. [Google Scholar] [CrossRef] [PubMed]
- Raghu, G.; Collard, H.R.; Egan, J.J.; Martinez, F.J.; Behr, J.; Brown, K.K.; Colby, T.V.; Cordier, J.-F.; Flaherty, K.R.; Lasky, J.A.; et al. An Official ATS/ERS/JRS/ALAT Statement: Idiopathic Pulmonary Fibrosis: Evidence-based Guidelines for Diagnosis and Management. Am. J. Respir. Crit. Care Med. 2011, 183, 788–824. [Google Scholar] [CrossRef]
- Societatea Românã de Pneumologie, Grupul de Lucru Pentru Pneumopatii Interstiþiale Difuze, and aI Sarcoidozã, Ghid de diagnostic si tratament al PID. 2015. Available online: https://www.srp.ro/ghiduri/Ghid%20de%20diagnostic%20si%20tratament%20al%20PID.pdf (accessed on 6 February 2022).
- Wells, A.U.; Brown, K.K.; Cottin, V. The progressive fibrotic phenotype in current clinical practice. Curr. Opin. Pulm. Med. 2021, 27, 368–373. [Google Scholar] [CrossRef] [PubMed]
- Wuyts, W.A.; Cavazza, A.; Rossi, G.; Bonella, F.; Sverzellati, N.; Spagnolo, P. Differential diagnosis of usual interstitial pneumonia: When is it truly idiopathic? Eur. Respir. Rev. 2014, 23, 308–319. [Google Scholar] [CrossRef] [PubMed]
- Idiopathic Pulmonary Fibrosis (an Update) and Progressive Pulmonary Fibrosis in Adults: An Official ATS/ERS/JRS/ALAT Clinical Practice Guideline. Available online: https://www.atsjournals.org/doi/epdf/10.1164/rccm.202202-0399ST (accessed on 24 August 2022).
- Fukihara, J.; Kondoh, Y.; Brown, K.K.; Kimura, T.; Kataoka, K.; Matsuda, T.; Yamano, Y.; Suzuki, A.; Furukawa, T.; Sumikawa, H.; et al. Probable usual interstitial pneumonia pattern on chest CT: Is it sufficient for a diagnosis of idiopathic pulmonary fibrosis? Eur. Respir. J. 2020, 55, 1802465. [Google Scholar] [CrossRef] [PubMed]
- Salisbury, M.L.; Tolle, L.B.; Xia, M.; Murray, S.; Tayob, N.; Nambiar, A.M.; Schmidt, S.L.; Lagstein, A.; Myers, J.L.; Gross, B.H.; et al. Possible UIP pattern on high-resolution computed tomography is associated with better survival than definite UIP in IPF patients. Respir. Med. 2017, 131, 229–235. [Google Scholar] [CrossRef] [PubMed]
- Jacob, J.; Bartholmai, B.J.; Rajagopalan, S.; Kokosi, M.; Nair, A.; Karwoski, R.; Walsh, S.L.; Wells, A.U.; Hansell, D.M. Mortality prediction in idiopathic pulmonary fibrosis: Evaluation of computer-based CT analysis with conventional severity measures. Eur. Respir. J. 2016, 49, 1601011. [Google Scholar] [CrossRef]
- Li, Q.; Cai, W.; Feng, D.D. Lung image patch classification with automatic feature learning. Annu. Int. Conf. IEEE Eng. Med. Biol. Soc. IEEE Eng. Med. Biol. Soc. Annu. Int. Conf. 2013, 2013, 6079–6082. [Google Scholar] [CrossRef]
- Broască, L.; Trușculescu, A.A.; Ancușa, V.M.; Ciocârlie, H.; Oancea, C.-I.; Stoicescu, E.-R.; Manolescu, D.L. A Novel Method for Lung Image Processing Using Complex Networks. Tomography 2022, 8, 1928–1946. [Google Scholar] [CrossRef]
- Nintedanib in Progressive Fibrosing Interstitial Lung Diseases|NEJM. Available online: https://www.nejm.org/doi/full/10.1056/NEJMoa1908681 (accessed on 26 August 2022).
- Wells, A.U.; Brown, K.K.; Flaherty, K.R.; Kolb, M.; Thannickal, V.J. What’s in a name? That which we call IPF, by any other name would act the same. Eur. Respir. J. 2018, 51, 1800692. [Google Scholar] [CrossRef]
- Hobbs, S.; Chung, J.H.; Leb, J.; Kaproth-Joslin, K.; Lynch, D.A. Practical Imaging Interpretation in Patients Suspected of Having Idiopathic Pulmonary Fibrosis: Official Recommendations from the Radiology Working Group of the Pulmonary Fibrosis Foundation. Radiol. Cardiothorac. Imaging 2021, 3, e200279. [Google Scholar] [CrossRef]
- Lynch, D.A.; Sverzellati, N.; Travis, W.D.; Brown, K.K.; Colby, T.V.; Galvin, J.R.; Goldin, J.G.; Hansell, D.M.; Inoue, Y.; Johkoh, T.; et al. Diagnostic criteria for idiopathic pulmonary fibrosis: A Fleischner Society White Paper. Lancet Respir. Med. 2018, 6, 138–153. [Google Scholar] [CrossRef]
- Alsumrain, M.; De Giacomi, F.; Nasim, F.; Koo, C.W.; Bartholmai, B.J.; Levin, D.L.; Moua, T. Combined pulmonary fibrosis and emphysema as a clinicoradiologic entity: Characterization of presenting lung fibrosis and implications for survival. Respir. Med. 2019, 146, 106–112. [Google Scholar] [CrossRef] [PubMed]
- Nonspecific Interstitial Pneumonia-Pulmonary Disorders. MSD Manual Professional Edition. Available online: https://www.msdmanuals.com/professional/pulmonary-disorders/interstitial-lung-diseases/nonspecific-interstitial-pneumonia (accessed on 13 February 2022).
- Tateishi, T.; Ohtani, Y.; Takemura, T.; Akashi, T.; Miyazaki, Y.; Inase, N.; Yoshizawa, Y. Serial High-Resolution Computed Tomography Findings of Acute and Chronic Hypersensitivity Pneumonitis Induced by Avian Antigen. J. Comput. Assist. Tomogr. 2011, 35, 272–279. [Google Scholar] [CrossRef] [PubMed]
- Selman, M. Hypersensitivity pneumonitis: A multifaceted deceiving disorder. Clin. Chest Med. 2004, 25, 531–547. [Google Scholar] [CrossRef] [PubMed]
- Silva, M.; Nunes, H.; Valeyre, D.; Sverzellati, N. Imaging of Sarcoidosis. Clin. Rev. Allergy Immunol. 2015, 49, 45–53. [Google Scholar] [CrossRef] [PubMed]
- Dhamija, E. Cryptogenic Organizing Pneumonia|Radiology Reference Article|Radiopaedia.org. Radiopaedia. Available online: https://radiopaedia.org/articles/cryptogenic-organising-pneumonia-1 (accessed on 1 July 2022).
- Baque-Juston, M.; Pellegrin, A.; Leroy, S.; Marquette, C.; Padovani, B. Organizing pneumonia: What is it? A conceptual approach and pictorial review. Diagn. Interv. Imaging 2014, 95, 771–777. [Google Scholar] [CrossRef]
- Signs and Patterns of Lung Disease-Chest Radiology: The Essentials, 2nd ed.; Available online: https://doctorlib.info/medical/chest/2.html (accessed on 6 February 2022).
- The Radiology Assistant: Basic Interpretation. Available online: https://radiologyassistant.nl/chest/hrct/basic-interpretation (accessed on 6 February 2022).
- Li, L.; Qin, L.; Xu, Z.; Yin, Y.; Wang, X.; Kong, B.; Bai, J.; Lu, Y.; Fang, Z.; Song, Q.; et al. Using artificial intelligence to detect COVID-19 and community-acquired pneumonia based on pulmonary CT: Evaluation of the diagnostic accuracy. Radiology 2020, 296, E65–E71. [Google Scholar] [CrossRef]
- Belfiore, M.P.; Urraro, F.; Grassi, R.; Giacobbe, G.; Patelli, G.; Cappabianca, S.; Reginelli, A. Artificial intelligence to codify lung CT in COVID-19 patients. Radiol. Med. 2020, 125, 500–504. [Google Scholar] [CrossRef]
- Grassi, R.; Belfiore, M.P.; Montanelli, A.; Patelli, G.; Urraro, F.; Giacobbe, G.; Fusco, R.; Granata, V.; Petrillo, A.; Sacco, P.; et al. COVID-19 pneumonia: Computer-aided quantification of healthy lung parenchyma, emphysema, ground glass and consolidation on chest computed tomography (CT). Radiol. Med. 2020, 126, 553–560. [Google Scholar] [CrossRef]
- Takahashi, M. Imaging of pulmonary emphysema: A pictorial review. Int. J. Chronic Obstr. Pulm. Dis. 2008, 3, 193–204. [Google Scholar] [CrossRef]
- Caltabiano, D.C.; Costanzo, V.; Mammino, L.; Vindigni, V.; Torrisi, S.; Rosso, R.; Mauro, L.A.; Vancheri, C.; Palmucci, S. Cystic pattern in lung diseases: A simplified HRCT guide based on free-hand drawings. In Proceedings of the ECR 2017 EPOS, 1 March 2017; Available online: https://epos.myesr.org/poster/esr/ecr2017/C-2141 (accessed on 13 February 2022).
- Fleischner Society: Glossary of Terms for Thoracic Imaging|Radiology. Available online: https://pubs.rsna.org/doi/abs/10.1148/radiol.2462070712?journalCode=radiology (accessed on 6 February 2022).
- Collins, J.; Stern, E.J. Alveolar Lung Disease-Chest Radiology: The Essentials, 2nd ed.; Available online: https://doctorlib.info/medical/chest/4.html (accessed on 6 February 2022).
- Torres, P.P.T.E.S.; Rabahi, M.F.; Moreira, M.A.D.C.; Escuissato, D.L.; Meirelles, G.D.S.P.; Marchiori, E. Importance of chest HRCT in the diagnostic evaluation of fibrosing interstitial lung diseases. J. Bras. Pneumol. 2021, 47, e20200096. [Google Scholar] [CrossRef]
- Dalpiaz, G.; Cancellieri, A. Alveolar Pattern. Atlas Diffuse Lung Dis. 2016, 145–162. [Google Scholar] [CrossRef]
- Ridge, C.A.; Bankier, A.A.; Eisenberg, R.L. Mosaic Attenuation. Am. J. Roentgenol. 2011, 197, W970–W977. [Google Scholar] [CrossRef] [PubMed]
- Gaillard, F. Head Cheese Sign (Lungs)|Radiology Reference Article|Radiopaedia.org. Radiopaedia. Available online: https://radiopaedia.org/articles/head-cheese-sign-lungs (accessed on 12 February 2022).
- Rossi, S.E.; Erasmus, J.J.; Volpacchio, M.; Franquet, T.; Castiglioni, T.; McAdams, H.P. “Crazy-Paving” Pattern at Thin-Section CT of the Lungs: Radiologic-Pathologic Overview. RadioGraphics 2003, 23, 1509–1519. [Google Scholar] [CrossRef]
- Gupta, N.; Vassallo, R.; Wikenheiser-Brokamp, K.A.; McCormack, F.X. Diffuse Cystic Lung Disease. Part II. Am. J. Respir. Crit. Care Med. 2015, 192, 17–29. [Google Scholar] [CrossRef] [PubMed]
- Desai, S.R.; Prosch, H.; Galvin, J.R. Plain Film and HRCT Diagnosis of Interstitial Lung Disease. In Diseases of the Chest, Breast, Heart and Vessels 2019–2022: Diagnostic and Interventional Imaging; Hodler, J., Kubik-Huch, R.A., von Schulthess, G.K., Eds.; Springer: Cham, Switzerland, 2019. Available online: http://www.ncbi.nlm.nih.gov/books/NBK553872/ (accessed on 6 February 2022).
- De Lima, G.V.L.; Castilho, T.R.; Bugatti, P.H.; Saito, P.T.M.; Lopes, F.M. A Complex Network-Based Approach to the Analysis and Classification of Images. In Progress in Pattern Recognition, Image Analysis, Computer Vision, and Applications; Springer: Cham, Switzerland, 2015; pp. 322–330. [Google Scholar] [CrossRef]
- Mourchid, Y.; El Hassouni, M.; Cherifi, H. A general framework for complex network-based image segmentation. Multimedia Tools Appl. 2019, 78, 20191–20216. [Google Scholar] [CrossRef]
- Costa, L.D.F.; Rodrigues, F.A.; Travieso, G.; Boas, P.R.V. Characterization of complex networks: A survey of measurements. Adv. Phys. 2007, 56, 167–242. [Google Scholar] [CrossRef]
- Nambiar, A.M.; Walker, C.M.; Sparks, J.A. Monitoring and management of fibrosing interstitial lung diseases: A narrative review for practicing clinicians. Ther. Adv. Respir. Dis. 2021, 15, 17534666211039772. [Google Scholar] [CrossRef] [PubMed]
- Quantitative CT Indexes in Idiopathic Pulmonary Fibrosis: Relationship with Physiologic Impairment|Radiology. Available online: https://pubs.rsna.org/doi/10.1148/radiol.2282020274?url_ver=Z39.88-2003&rfr_id=ori:rid:crossref.org&rfr_dat=cr_pub%20%200pubmed (accessed on 28 August 2022).
- Zrimec, T.; Busayarat, S. Computer-aided Analysis and Interpretation of HRCT Images of the Lung. In Theory and Applications of CT Imaging and Analysis; Homma, N., Ed.; IntechOpen: London, UK, 2011; ISBN 978-953-307-234-0. [Google Scholar] [CrossRef]
- Depeursinge, A.; Zrimec, T.; Busayarat, S.; Müller, H. 3D Lung Image Retrieval Using Localized Features. In Proceedings of the SPIE Medical Imaging 2011: Computer-Aided Diagnosis, Orlando, FL, USA, 12–17 February 2011. [Google Scholar] [CrossRef]
- Humphries, S.M.; Yagihashi, K.; Huckleberry, J.; Rho, B.-H.; Schroeder, J.D.; Strand, M.; Schwarz, M.I.; Flaherty, K.R.; Kazerooni, E.A.; Van Beek, E.J.R.; et al. Idiopathic Pulmonary Fibrosis: Data-driven Textural Analysis of Extent of Fibrosis at Baseline and 15-Month Follow-up. Radiology 2017, 285, 270–278. [Google Scholar] [CrossRef]
- Kim, H.J.; Brown, M.S.; Chong, D.; Gjertson, D.W.; Lu, P.; Kim, H.J.; Coy, H.; Goldin, J.G. Comparison of the Quantitative CT Imaging Biomarkers of Idiopathic Pulmonary Fibrosis at Baseline and Early Change with an Interval of 7 Months. Acad. Radiol. 2015, 22, 70–80. [Google Scholar] [CrossRef]

| HU Layer | Total Count VS DLCO | Average Count VS DLco | Parameters |
|---|---|---|---|
| E | 1.81144865 | 2.297734923 | t Stat |
| 0.038529988 | 0.013194925 | P(T ≤ t) one-tail | |
| 2.016692199 | 2.015367574 | t Critical two-tail | |
| GGO | −1.334981884 | −1.82528253 | t Stat |
| 0.092702764 | 0.035714932 | P(T ≤ t) one-tail | |
| 1.987934206 | 1.987934206 | t Critical two-tail | |
| C | −1.334981884 | −1.82528253 | t Stat |
| 0.093421672 | 0.035996812 | P(T ≤ t) one-tail | |
| 1.999623585 | 1.992543495 | t Critical two-tail |
| Layer | Max Degree | Total Count | Average Count | Parameters |
|---|---|---|---|---|
| E | −0.357327012 | −0.33960631 | −1.194455411 | t Stat |
| 0.361362738 | 0.367964892 | 0.119667428 | P(T ≤ t) one-tail | |
| 2.02107539 | 2.02107539 | 2.02107539 | t Critical two-tail | |
| GGO | 2.362901118 | 2.496174465 | 2.132901092 | t Stat |
| 0.016568972 | 0.012345754 | 0.023097162 | P(T ≤ t) one-tail | |
| 2.144786688 | 2.131449546 | 2.093024054 | t Critical two-tail | |
| C | 2.787128882 | 2.910253494 | 1.723111496 | t Stat |
| 0.006593367 | 0.005384188 | 0.048371727 | P(T ≤ t) one-tail | |
| 2.119905299 | 2.131449546 | 2.055529439 | t Critical two-tail |
Publisher’s Note: MDPI stays neutral with regard to jurisdictional claims in published maps and institutional affiliations. |
© 2022 by the authors. Licensee MDPI, Basel, Switzerland. This article is an open access article distributed under the terms and conditions of the Creative Commons Attribution (CC BY) license (https://creativecommons.org/licenses/by/4.0/).
Share and Cite
Trușculescu, A.A.; Manolescu, D.L.; Broască, L.; Ancușa, V.M.; Ciocârlie, H.; Pescaru, C.C.; Vaștag, E.; Oancea, C.I. Enhancing Imagistic Interstitial Lung Disease Diagnosis by Using Complex Networks. Medicina 2022, 58, 1288. https://doi.org/10.3390/medicina58091288
Trușculescu AA, Manolescu DL, Broască L, Ancușa VM, Ciocârlie H, Pescaru CC, Vaștag E, Oancea CI. Enhancing Imagistic Interstitial Lung Disease Diagnosis by Using Complex Networks. Medicina. 2022; 58(9):1288. https://doi.org/10.3390/medicina58091288
Chicago/Turabian StyleTrușculescu, Ana Adriana, Diana Luminița Manolescu, Laura Broască, Versavia Maria Ancușa, Horia Ciocârlie, Camelia Corina Pescaru, Emanuela Vaștag, and Cristian Iulian Oancea. 2022. "Enhancing Imagistic Interstitial Lung Disease Diagnosis by Using Complex Networks" Medicina 58, no. 9: 1288. https://doi.org/10.3390/medicina58091288
APA StyleTrușculescu, A. A., Manolescu, D. L., Broască, L., Ancușa, V. M., Ciocârlie, H., Pescaru, C. C., Vaștag, E., & Oancea, C. I. (2022). Enhancing Imagistic Interstitial Lung Disease Diagnosis by Using Complex Networks. Medicina, 58(9), 1288. https://doi.org/10.3390/medicina58091288







